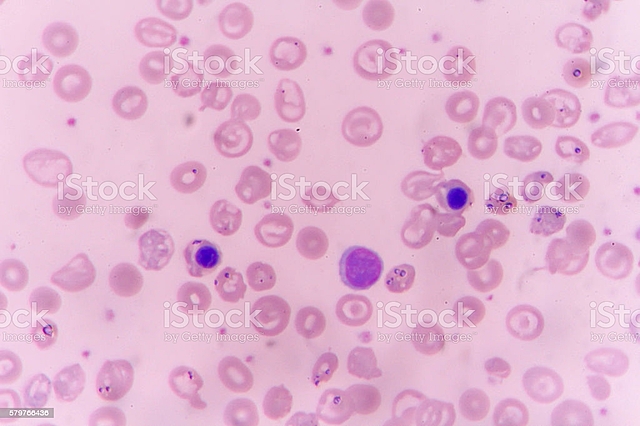
Henle

-
Hermanos Jansen
-
Formado por 2 tubos y 2 lentes por Hans Jassen y su hijo Zacharias Jassen
-
Dibuja los órganos de una abeja
-
Fabrica un microscopio con un reflector cóncavo que iluminaba el objeto.
-
Robert Hooke (1635-1703)
-
En su obra “Tractatus de natura substantiae”, dice que la fibra es la portadora de la vida formal y funcional.
-
Descubre la Vortichella
-
Marcelo Malpighi y Nehmiah Grew, observan células en los órganos vegetales
-
Descubre el Paramecium.
-
En su obra Voyage en Vestrogothie propone que todos los seres vivos están compuestos por humus.
-
Descubre la amiba.
-
Retoma las ideas de Glisson y menciona que la fibra es la unidad fundamental de la vida. Hace la teoría fibrilar.
-
Formulan el concepto tisular en donde proponen que hay 21 tejidos que forman el cuerpo humano.
-
En su obra “la generación” plantea la Teoría infusorial donde establece que el cuerpo está formado por una sustancia primigenia que es un fluido mucoide (Urschleim).
-
Propone que la célula es la pieza fundamental del organismo y sus características, se le considera como el verdadero creador de la teoría celular, pero no tuvo los medios necesarios para que esta fuera recibida.
-
Propone en su obra “Organographie microscopique elementaire et comaree des vegetaux” que las células pueden vivir aisladamente y que pueden aglomerarse con otras para hacer un ser más complejo (organismo) este es una individualidad compuesta.
-
En su obra "Phytotomie" dice que la célula es un organismo individual, pero todas las células forman un todo completo que existe por si mismo y sus características.
-
Con las células epidermis de la flor de las orquídeas descubre el núcleo celular
-
Jan Evangeliste Purkinje y Gabriel Gustav Valentín
-
Describe células nucleadas en una gran cantidad de tejidos humanos
-
Describe la división celular en algas.
-
En su obra la "fitogenesis" cita el trabajo de Brown para concluir que todas las células proceden de citoblasto, se organizan y se estructura por medio de su núcleo.
-
Publica “investigaciones microscópicas”, propone la teoría celular donde menciona que la célula es la unidad fundamental de los seres vivos y las características de esta.
-
Crea y utiliza el termino protoplasma
-
Define a los protozoarios como animales constituidos por una sola célula.
-
Considera que el desarrollo es consecuencia de la división celular del huevo.
-
Precisa que el proceso celular se lleva a cabo en el núcleo a través de atracción molecular
-
Establece que la célula no es una unidad anatómica y fisiológica, sino la unidad de todos los seres vivos.
-
Establece que el espermatozoide es una célula
-
Introduce el reino del protista conformado por organismos unicelulares
-
Utiliza en el termino sarcoda en vez de protoplasma para referirse a una gelatina viviente, contráctil suseptible.
Plan projects on a visual timeline
Map milestones, phases, deadlines, and key events in one place so the sequence is easier to see and share. Timetoast is a timeline maker for work, school, research, and stories.